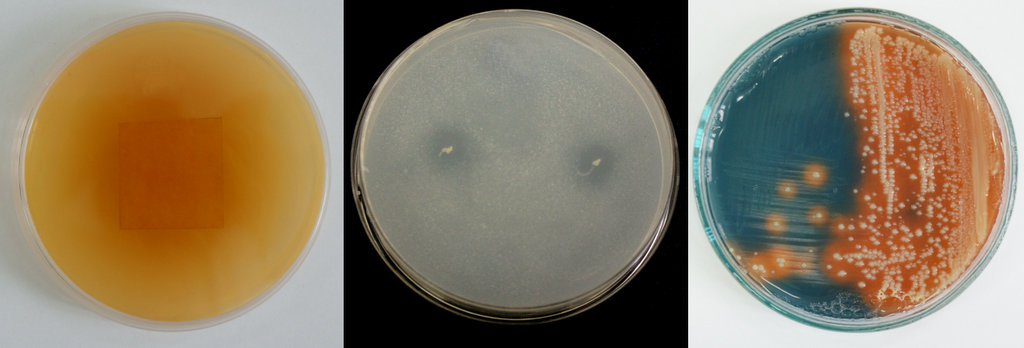

Wyobraźmy sobie, że doszło do wycieku oleju opałowego w domu jednorodzinnym. W wyniku tego zdarzenia zanieczyszczony został teren zlokalizowany pod budynkiem. Obiekt okopano, następnie za pomocą systemu drenażowego wprowadzono do gleby odpowiednio wyselekcjonowane bakterie, by potem przez kilka miesięcy monitorować stopniowe oczyszczenie ziemi. Polska? Jeszcze nie. To fiński przykład stosowania biologicznych metod oczyszczania skażonych terenów. Na Uniwersytecie Śląskim metody te rozwijają dr Magdalena Pacwa-Płociniczak oraz dr Tomasz Płociniczak.
Wspomniany przykład został zaprezentowany podczas warsztatów zorganizowanych w ubiegłym roku na Uniwersytecie w Helsinkach (Finlandia) w ramach europejskiego projektu naukowego pn. „International TANIA Symposium – Novel Environmental Remediation Techniques and Policy Instruments”. Jednym z uczestników był dr Tomasz Płociniczak.
– Z przyjemnością słuchałem opowieści o rozwiązaniach, które u nas w Polsce wciąż jeszcze budzą zbyt małe zainteresowanie wśród osób borykających się z zanieczyszczonymi glebami – mówi biolog z Wydziału Nauk Przyrodniczych UŚ. – Mowa o naturalnych metodach oczyszczania obszarów skażonych związkami zarówno organicznymi, jak również nieorganicznymi, takimi jak węglowodory czy metale ciężkie. Od wielu lat wraz żoną interesujemy się możliwościami wykorzystania bakterii i roślin w remediacji.
Naukowcy z jednej strony prowadzą badania, udoskonalając znane metody, z drugiej – intensywnie współpracują z firmami, prywatnymi właścicielami czy jednostkami samorządowymi, aby wykorzystać zdobytą wiedzę w praktyce i na tej podstawie proponować najlepsze rozwiązania dopasowane do potrzeb klienta. Najważniejsze jest poszukiwanie możliwie najbezpieczniejszej dla środowiska naturalnego drogi, która w sposób nieinwazyjny pozwoli oczyścić dany obszar z różnego rodzaju zanieczyszczeń.
Dr Magdalena Pacwa-Płociniczak, realizując wcześniejszy projekt, zajmowała się przede wszystkim analizą możliwości wykorzystania różnych szczepów bakterii w oczyszczaniu gleby ze związków organicznych. Biolożka izolowała bakterie, aby następnie w laboratorium sprawdzać, które z nich mają największy potencjał w bioremediacji oraz w jaki sposób są w stanie przetrwać w nawet bardzo trudnych warunkach.
– Wiedziałam, że mąż bada rośliny mogące również wspomagać interesujące mnie procesy. Połączyliśmy siły i zaczęliśmy wspólnie pracować nad udoskonaleniem naturalnych, biologicznych metod oczyszczania terenów skażonych związkami organicznymi i nieorganicznymi z wykorzystaniem mikroorganizmów i odpowiednio dobranych gatunków roślin – mówi badaczka.
Nie ma dwóch takich samym obszarów, jeśli chodzi o rodzaj i stężenie zanieczyszczeń. Każde środowisko ma też pewien unikatowy „zestaw” mikroorganizmów dostosowujących się do zastanych warunków. To ważna podpowiedź natury. Co więcej, na takim terenie mogą rosnąć również różne gatunki roślin przyspieszające i wspomagające proces remediacji. Do tego pakietu wiedzy wystarczy jeszcze dodać odrobinę pomysłowości, aby zaproponować skuteczne, bezpieczne dla środowiska rozwiązania.
– Kiedy zgłasza się do nas właściciel obszaru przeznaczonego do oczyszczania i jest zainteresowany zastosowaniem biologicznych metod oczyszczania, najpierw musimy dokładnie zbadać wskazany teren i zastanowić się, jaki „zestaw” zaoferować – mówi dr Magdalena Pacwa-Płociniczak.
Jedna z osób, z którą współpracowali naukowcy, poprosiła o zaprojektowanie rozwiązania dla zanieczyszczonego obszaru zlokalizowanego w województwie opolskim.
– Co ciekawe, była to osoba znająca potencjał metod bioremediacyjnych. Może dlatego nie musieliśmy jej przekonywać do zalet wynikających ze stosowania naturalnych technik – dodaje, uśmiechając się, dr Tomasz Płociniczak.
Najpierw zostały pobrane i zbadane próbki gleby. Naukowcy musieli zidentyfikować rodzaje zanieczyszczeń i ich stężenia oraz sprawdzić, jakie mikroorganizmy występują na tym terenie.
Po lewej: zdolność do wytwarzania kwasu cyjanowodorowego (pomarańczowe zabarwienie bibuły).
W środku: rozpuszczanie fosforanu trójwapniowego (strefy przejaśnień wokół kolonii).
Po prawej: zdolność do wytwarzania sideroforów wiążących żelazo (pomarańczowe zabarwienie wokół kolonii)
– To jedno z najważniejszych pytań. W opracowywanej metodzie staramy się bowiem korzystać z tych mikroorganizmów, które już zamieszkują dany teren. Wprowadzenie innych mogłoby doprowadzić do lokalnych „walk” i przyczynić się tym samym do obniżenia skuteczności metody – wyjaśnia dr Magdalena Pacwa-Płociniczak.
Omawiany przypadek wymagał dodatkowo konsultacji z geologiem. Okazało się, że znajdująca się w pobliżu instalacja utraciła szczelność i zanieczyszczenia nieustannie napływały, sprawiając, że stężenie substancji zanieczyszczających glebę rosło. Jednorazowe oczyszczenie tego terenu nie przyniosłoby więc spodziewanych i trwałych rezultatów.
Znając odpowiedzi na najważniejsze pytania, dr Tomasz Płociniczak zaproponował zbudowanie sześciu specjalnych studni.
– Gromadziła się w nich zanieczyszczona woda z wyznaczonego obszaru. Do nich aplikowaliśmy również pożyteczne mikroorganizmy wyizolowane z tego terenu, o których wiedzieliśmy, że potrafią rozkładać zanieczyszczenia organiczne. Woda była też napowietrzana i podgrzewana, aby warunki sprzyjały namnażaniu wyselekcjonowanych przez nas organizmów – tłumaczy naukowiec.
Oczyszczoną w ten sposób wodę rozlewano następnie na skażonym terenie. Woda infiltrowała glebę i wraz z kolejnymi zanieczyszczeniami trafiała ponownie do studni, a cały proces zaczynał się od początku.
– Zaproponowaliśmy zatem układ zamknięty biologicznego oczyszczania gleby skażonej substancjami organicznymi, z zastosowaniem wody jako nośnika zanieczyszczeń i zarazem pożytecznych bakterii – dodaje.
Biologiczne metody oczyszczania terenów skażonych związkami organicznymi i nieorganicznymi są wciąż mało popularne w naszym kraju. Biolodzy z Uniwersytetu Śląskiego bez wahania wskazują cztery czynniki, które mogą mieć na to wpływ.
Po pierwsze: nie jest to rozwiązanie uniwersalne. Naukowcy nie stosują gotowych biologicznych „szczepionek”, choć i takie są przecież dostępne na rynku. Każdy przypadek traktują indywidualnie, muszą najpierw zbadać skażony obszar pod kątem rodzaju i stężenia zanieczyszczeń oraz występujących w nim mikroorganizmów. Zdarza się, że specyfika terenu wymaga dodatkowych konsultacji, jak w przypadku z województwa opolskiego, co może generować dodatkowe koszty. To rozwiązania szyte na miarę, cena idzie więc w parze z jakością.
Po drugie: działanie mikroorganizmów i roślin wymaga czasu. Zdarza się, że klient może poczekać na efektywność metody biologicznej. Rekultywowana hałda przeznaczona na tereny rekreacyjne dla mieszkańców nie musi być udostępniona w ciągu jednego miesiąca, jej przygotowanie może potrwać nawet kilka lat, jeśli nadrzędną wartością jest troska o środowisko naturalne. Inaczej jest z właścicielami, którzy chcą jak najszybciej rozpocząć realizację swoich planów.
– Co robią? Wynajmują ciężarówki i wykonują kilkaset kursów z zanieczyszczoną ziemią, przewożąc ją w inne miejsce. Następnie w miejsce to przywozi się nieskażoną glebę. Takie działanie z pewnością zajmuje mniej czasu, ale jest droższe i przede wszystkim zaburza naturalną równowagę biologiczną. Co zyskujemy w zamian? Wybrana ziemia nie znika, musi gdzieś trafić, a ponadto rzadko zdarza się, aby skażony był tylko teren przeznaczony na przykład pod budowę obiektów. Z czasem szkodliwe związki organiczne czy nieorganiczne z powrotem dotrą różnymi naturalnymi drogami do tego miejsca, a właściciel terenu wróci do punktu wyjścia – komentuje dr Tomasz Płociniczak.
Po trzecie: skuteczność. Naukowcy mają świadomość wyzwań, jakie wiążą się ze stosowaniem biologicznych metod oczyszczania terenów skażonych.
– Nie do końca jesteśmy w stanie okiełznać naturę. „Do pracy” angażujemy rośliny i/lub mikroorganizmy. Badania trwają, wciąż poznajemy mechanizmy pozwalające organizmom przetrwać w skażonej glebie. Proces bioremediacji musi być więc monitorowany i może wymagać stosowania różnych usprawnień czy modyfikacji. Jesteśmy na to przygotowani – mówi dr Magdalena Płociniczak.
A nade wszystko: świadomość. Naukowcy z żalem przyznają, że troska o środowisko naturalne w Polsce to niestety wciąż raczkujący temat. W wielu innych europejskich krajach nie trzeba nikogo przekonywać do przewagi metod biologicznych, wybranych zgodnie ze specyfiką danego obszaru, niezmieniających jego charakteru, przyczyniających się do zachowania tak ważnej przecież bioróżnorodności.
Małgoprzata Kłoskowicz
Artykuł został opublikowany w "Gazecie Uniwersyteckiej UŚ" [nr 4 (284) styczeń 2021]

